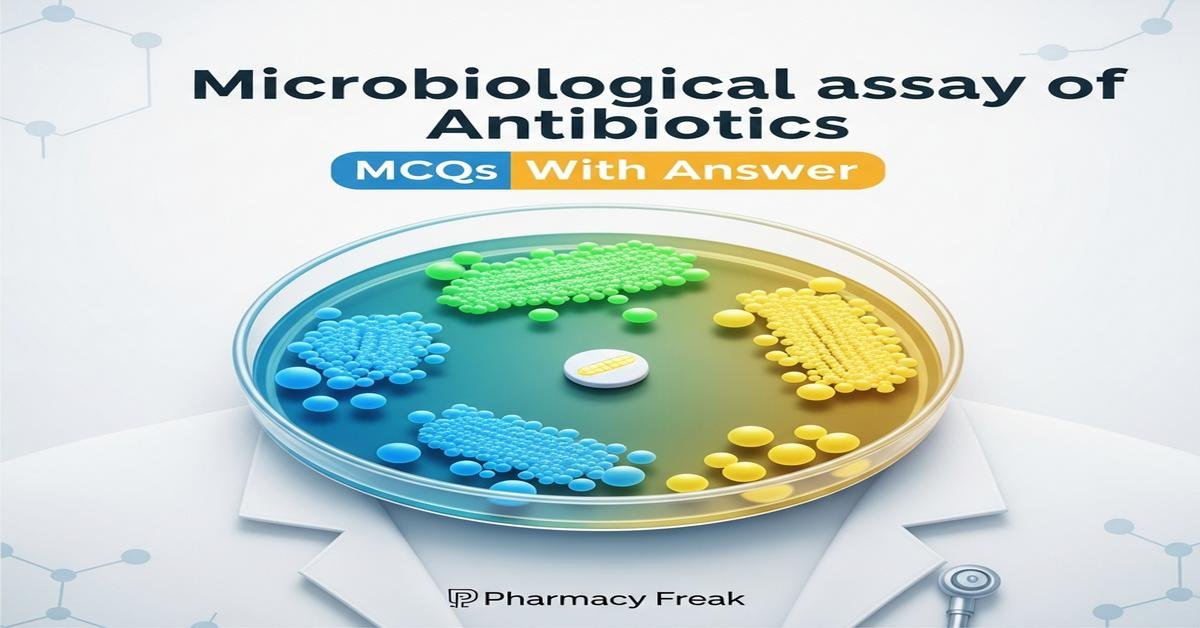
Microbiological assay of antibiotics MCQs With Answer

Introduction
This quiz collection on Microbiological Assay of Antibiotics is designed for M.Pharm students preparing for exams and practicals in Biological Evaluation of Drug Therapy. It covers core principles, common assay formats (agar diffusion, turbidimetric, and plate count), selection of indicator organisms, factors influencing assay precision, and interpretation using statistical bioassay methods. Questions emphasize experimental design, validation parameters, and troubleshooting to build deeper conceptual understanding and laboratory competence. Use these MCQs to test knowledge, identify weak areas, and reinforce best practices for accurate and reproducible microbiological potency determination of antibiotic preparations.
Q1. Which principle best describes the agar diffusion (cup-plate) method used in microbiological assays of antibiotics?
- Quantification by measuring optical density change in broth culture
- Formation of a clear zone around a point source due to antibiotic diffusion and microbial inhibition
- Counting colony forming units after serial dilution and plating
- Measurement of antibiotic binding to a chemical indicator dye
Correct Answer: Formation of a clear zone around a point source due to antibiotic diffusion and microbial inhibition
Q2. In a turbidimetric microbiological assay, the endpoint used to measure antibiotic effect is:
- Diameter of inhibition zone on agar
- Change in optical density (turbidity) of liquid culture
- Number of inhibited colonies on selective agar
- Mass of precipitated antibiotic complex
Correct Answer: Change in optical density (turbidity) of liquid culture
Q3. Which factor is most critical to standardize when preparing agar plates for diffusion assays to ensure reproducible zone sizes?
- Color of the agar
- Agar depth and composition (thickness and nutrient content)
- Ambient room temperature during incubation
- Brand of Petri dishes used
Correct Answer: Agar depth and composition (thickness and nutrient content)
Q4. The most appropriate indicator organism for assaying a broad-spectrum beta-lactam antibiotic using agar diffusion is typically:
- Escherichia coli sensitive strain
- Pseudomonas aeruginosa resistant strain
- Staphylococcus aureus MRSA strain
- Mycobacterium tuberculosis strain
Correct Answer: Escherichia coli sensitive strain
Q5. In a microbiological assay, parallel line analysis is used primarily to:
- Visualize colonies with higher resolution
- Compare log-dose response curves of standard and sample to estimate potency
- Reduce contamination during plating
- Determine minimum inhibitory concentration (MIC) in µg/mL directly
Correct Answer: Compare log-dose response curves of standard and sample to estimate potency
Q6. Which outcome indicates non-parallelism in a potency assay and invalidates straightforward relative potency estimation?
- Standard and sample dose–response lines have identical slopes
- Standard and sample dose–response lines are statistically significantly different in slope
- Both standard and sample show no biological activity
- Standard responses are consistently higher by a fixed amount than sample responses
Correct Answer: Standard and sample dose–response lines are statistically significantly different in slope
Q7. Which of the following is a main advantage of microbiological assays over chemical assays for antibiotics?
- They are faster and require no incubation time
- They measure biological activity, reflecting the actual antimicrobial potency
- They do not require standard reference materials
- They are unaffected by assay conditions such as pH or inoculum size
Correct Answer: They measure biological activity, reflecting the actual antimicrobial potency
Q8. Which variable most directly affects diffusion rate of antibiotic in agar during disk or cup-plate assays?
- Concentration of agarose in the gel
- Length of incubation time only
- Color of the inoculum suspension
- Brand of micropipette tips
Correct Answer: Concentration of agarose in the gel
Q9. When constructing a standard curve for a turbidimetric assay, the relationship plotted is usually:
- Antibiotic concentration versus zone diameter
- Logarithm of antibiotic concentration versus response (optical density change)
- Time of incubation versus colony count
- pH versus antibiotic stability
Correct Answer: Logarithm of antibiotic concentration versus response (optical density change)
Q10. What is the primary purpose of including a negative control (no antibiotic) in a microbiological assay?
- To provide an internal standard for potency calculation
- To confirm growth conditions and viability of the indicator organism
- To act as a diluent for antibiotic samples
- To measure the color change induced by antibiotics
Correct Answer: To confirm growth conditions and viability of the indicator organism
Q11. The cup-plate method differs from disk diffusion mainly because:
- Cup-plate uses liquid antibiotic in wells, while disk diffusion uses impregnated disks
- Cup-plate does not rely on diffusion principles
- Disk diffusion requires serial dilution plates
- Cup-plate measures turbidity rather than zones
Correct Answer: Cup-plate uses liquid antibiotic in wells, while disk diffusion uses impregnated disks
Q12. Which assay parameter would you adjust if you observe consistently smaller zones of inhibition for both standard and test samples, indicating low apparent potency?
- Increase incubation humidity only
- Verify and adjust pH of medium, inoculum density, and agar depth
- Change the brand of antibiotic standard
- Use a different color indicator dye
Correct Answer: Verify and adjust pH of medium, inoculum density, and agar depth
Q13. In potency expression for antibiotics determined by microbiological assay, the unit commonly reported is:
- mg of active ingredient per mL without biological reference
- Relative potency compared to a certified reference standard (percentage or IU)
- Optical density units at 600 nm
- Colony forming units per mL (CFU/mL)
Correct Answer: Relative potency compared to a certified reference standard (percentage or IU)
Q14. Which of the following best explains why MIC and microbiological potency are related but not identical?
- MIC measures toxicity to eukaryotic cells while potency measures bacterial growth
- MIC is a susceptibility endpoint for a specific strain, while potency reflects the overall biologically active content relative to a standard
- MIC is measured by diffusion, potency only by chromatographic methods
- They are identical; both terms can be used interchangeably
Correct Answer: MIC is a susceptibility endpoint for a specific strain, while potency reflects the overall biologically active content relative to a standard
Q15. During validation of a microbiological assay, which parameter assesses the closeness of agreement between repeated measurements?
- Specificity
- Precision (repeatability and intermediate precision)
- Robustness only
- Linearity slope value alone
Correct Answer: Precision (repeatability and intermediate precision)
Q16. Buffering capacity of the assay medium is important because pH shifts can:
- Only change the color of the medium but not affect antibiotic activity
- Alter solubility and activity of the antibiotic and affect microbial growth
- Prevent diffusion through agar regardless of antibiotic chemistry
- Only influence incubation temperature
Correct Answer: Alter solubility and activity of the antibiotic and affect microbial growth
Q17. Which statistical test is commonly applied to check the linearity and parallelism assumptions in bioassay analysis?
- Chi-square goodness of fit
- Analysis of variance (ANOVA) applied to dose–response data
- Kruskal–Wallis nonparametric test
- Kaplan–Meier survival analysis
Correct Answer: Analysis of variance (ANOVA) applied to dose–response data
Q18. For antibiotics that are poorly diffusible in agar, which microbiological assay is preferred?
- Agar diffusion disk method
- Turbidimetric or broth dilution assays
- Paper chromatography assay
- Disk diffusion with UV exposure
Correct Answer: Turbidimetric or broth dilution assays
Q19. When preparing a standard curve in an agar diffusion assay, which transformation often linearizes the relationship between concentration and inhibition zone?
- Plot zone area versus raw concentration
- Plot zone diameter against logarithm of concentration
- Plot square root of diameter against pH
- Plot concentration versus incubation time
Correct Answer: Plot zone diameter against logarithm of concentration
Q20. Which precaution is essential to minimize variability caused by inoculum preparation in microbiological assays?
- Use cultures from different growth phases for each replicate
- Standardize inoculum turbidity using a McFarland standard or spectrophotometer
- Adjust inoculum only by visual inspection without instrumentation
- Freeze and thaw inoculum before each assay
Correct Answer: Standardize inoculum turbidity using a McFarland standard or spectrophotometer